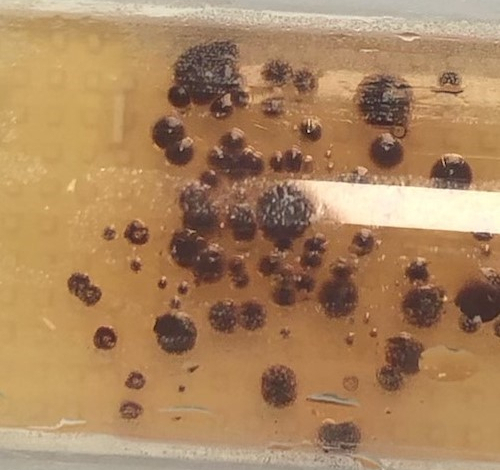

Le jeudi 20 janvier 2022, les élèves de première spécialité SVT ont participé au jeudi de la science à UniLasalle. Une occasion pour les élèves de découvrir des domaines scientifiques innovants et essentiels dans les activités humaines.
En amont de cette sortie, Ils ont pu mettre en culture les souches bactériennes présentent sur leur main mais aussi sur divers supports.
Ils ont ainsi mesuré l’effet de différents produits sur la prolifération antibactérienne. Ils ont pu observer différentes moisissures et les caractériser au niveau macroscopique et microscopique dans le cadre de l’utilisation des microorganismes dans l’agroalimentaire. Lire le compte rendu de la journée